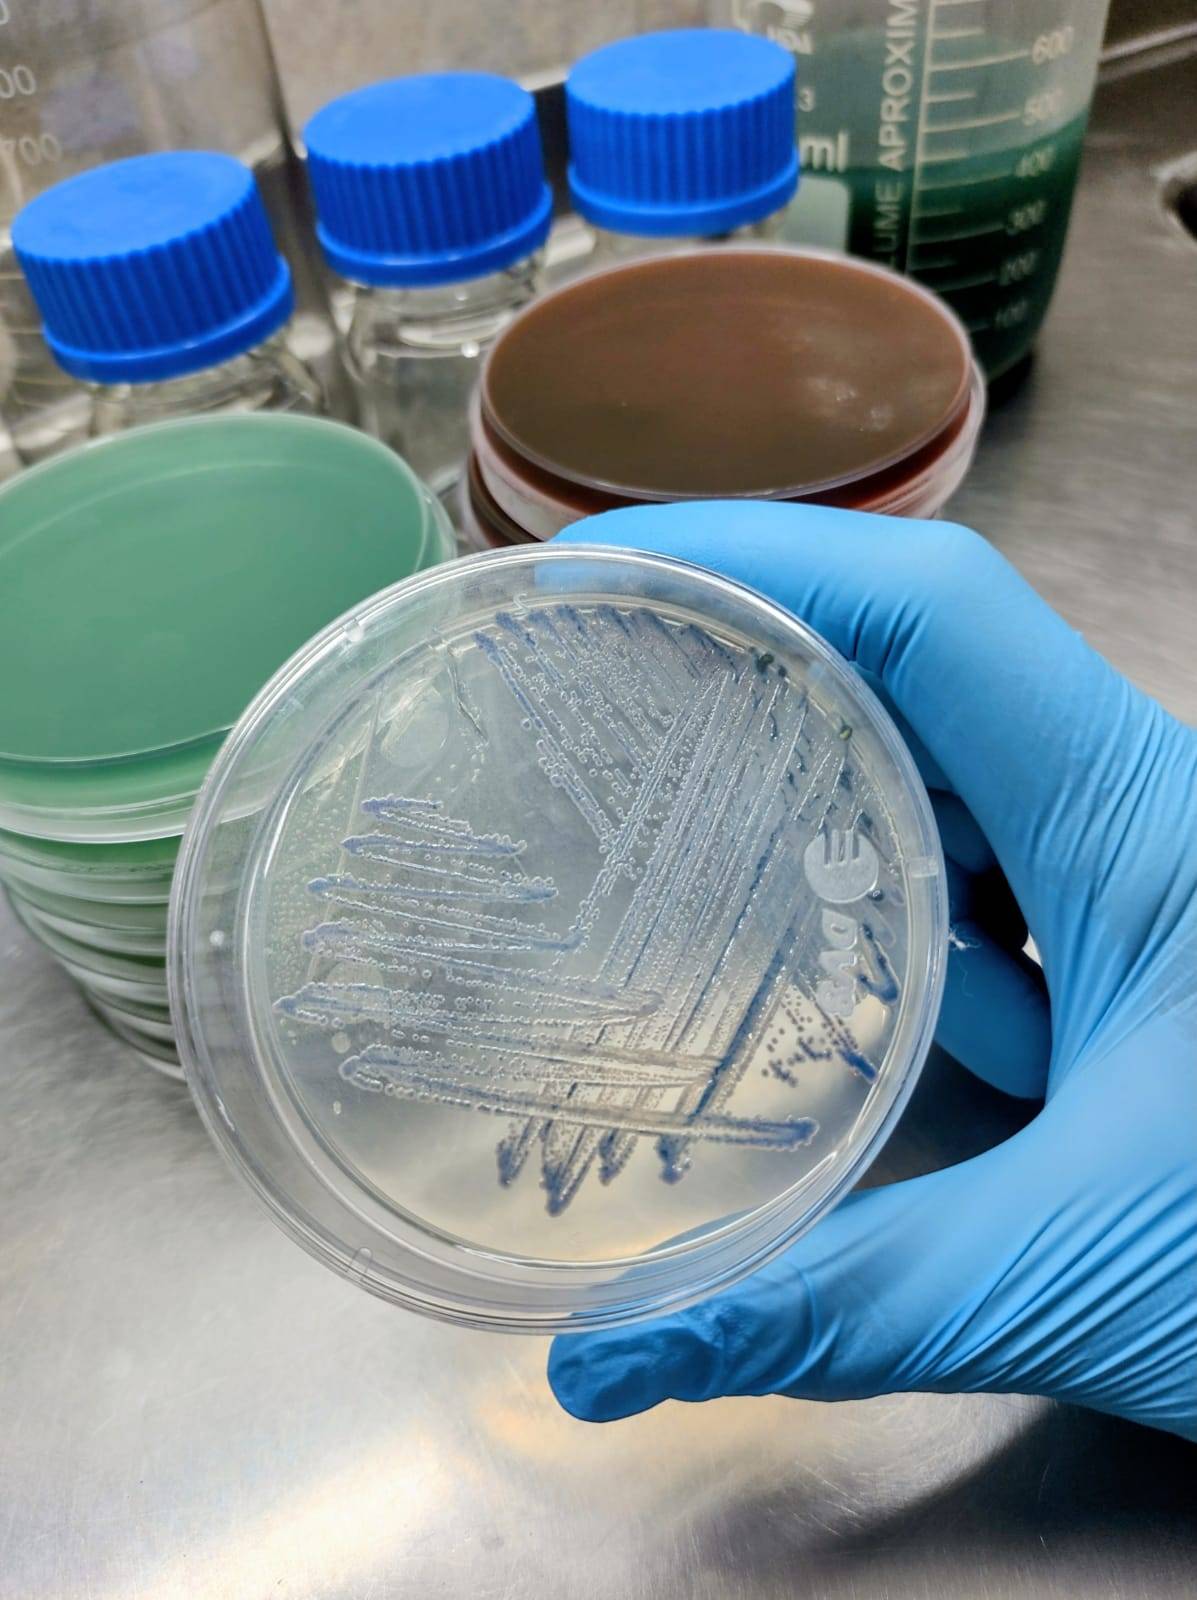

Slide 1
Laboratorio Forastiere
Laboratorio Forastiere con 27 años de experiencia y vocación de servicio
Slide 2
Valorando la confianza y la satisfacción de nuestros pacientes, esforzándonos por superar sus expectativas
Slide 3
“Calidez en la atención. Calidad en los resultados”
Laboratorio Forastiere con 27 años de experiencia y vocación de servicio, valorando la confianza y la satisfacción de nuestros pacientes, esforzándonos por superar sus expectativas
“Calidez en la atención. Calidad en los resultados”
Dirección
Italia 1180, Luján, Buenos Aires
Extracciones
Lunes a Viernes de 7:30 a 9:00 hs.
Sábados de 7:30 a 8:30 hs. (con turno previo)
Horarios
Lunes a Viernes de 7:30 a 18:00 hs.
Sábados de 7:30 a 12:00 hs.
EXCELENTETrustindex verifica que la fuente original de la reseña sea Google. Muy buen servicio, desde la recepción hasta la entrega de resultados. Siempre me realizaron las extracciones con mucha delicadeza.Publicado enTrustindex verifica que la fuente original de la reseña sea Google. Excelente atención!!!! Muy amables todos . Super conformePublicado enTrustindex verifica que la fuente original de la reseña sea Google. Excelente lugar, tanto las administrativas como los bioquímicos son muy amables y cordial en el trato. Es un laboratorio muy confiable por todas sus certificaciones.Publicado enTrustindex verifica que la fuente original de la reseña sea Google. El mejor laboratorio su atención delante del mostrador como los profesionales es excelente. Brindando una calidad humana al momento de ser atendidoPublicado enTrustindex verifica que la fuente original de la reseña sea Google. Muy buena la atenciónPublicado enTrustindex verifica que la fuente original de la reseña sea Google. Es el único lugar donde me encuentran las venas!!Publicado enTrustindex verifica que la fuente original de la reseña sea Google. Desde hace más de 10 años elijo Laboratorio Forastiere como lugar de atención para análisis clínicos por la calidad con la que se observa que trabajan y la calidez con que reciben a uno para ser atendido. Muy atentos en enviar por whatsapp los resultados de los estudios cuando se elige de esa forma, porque la verdad ahorra bastante tiempo. Paula, la recepcionista, marca un diferencial por lo amable en su trato y de igual manera el resto de profesionales que ahí trabajan. El laboratorio es un sitio de referencia dentro de las otras opciones existentes en Luján y además está acreditado.Publicado enTrustindex verifica que la fuente original de la reseña sea Google. Desastre 40 minutos para tomar la orden!!!!!! Y sigo esperando para hacerme el analisis de sangre. Y se va colando gente en el medio. Estan desactualizados en personal y en tiempos. 2 horas para dejar orina y sangre. Una locura. Mas de 30 personas en dos ambientes, con lo que esta pasando de los virus y germenes. O aceleran o se quedan en 1910.Publicado enTrustindex verifica que la fuente original de la reseña sea Google. Muy buena atenciónPublicado enTrustindex verifica que la fuente original de la reseña sea Google. Excelente atención! Tanto los profesionales como en recepción, el trato es impecable. Amables y profesionales.
